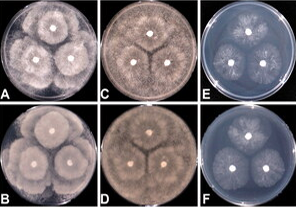
韓國耐高溫真菌和卵菌的研究

搜索結(jié)果: 70
sCMOS相機丨Dhyana XF95氣體高次諧波 (HHG) 信號探測
2467
鑫圖TrueChrome II攜手央視見證湟魚寶寶誕生過程
1547
鑫圖Dhyana相機助力CCTV直播月全食奇觀
1561
高混濁水中光信標(biāo)跟蹤及其在水下船塢中的應(yīng)用
2377
一種用于神經(jīng)刺激的磁芯微型螺線管的開發(fā)
1932
韓國耐高溫真菌和卵菌的研究
1871
一種快速的相干反斯托克斯拉曼散射顯微鏡
2040
一種雙通道的高性能光譜儀的研究
1776
一種光熱療法抑制癌細胞轉(zhuǎn)移的研究
1924
觀測空間碎片的小型望遠鏡系統(tǒng)
1770
通過偏振光結(jié)構(gòu)光顯微鏡對熒光偶極子進行超分辨率成像的研究
2314
偏振光下水合萜二醇
1766
工業(yè)測量
1907
偏光骨骼組織切片
1779
腎臟細胞
1693
神經(jīng)元細胞
1559
果蠅效果圖
1588
醫(yī)療病理組織
1863
老鼠組織切片
1660
體視觀察
1817